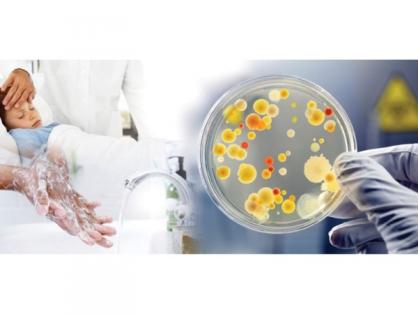

Через російську військову агресію, затоплення житлових та сільськогосподарських територій, руйнування об'єктів критичної інфраструктури, а також з настанням теплого періоду року збільшується ризик ускладнення санітарно-епідемічної ситуації щодо виникнення гострих кишкових інфекційних захворювань та харчових отруєнь серед населення.
Через російську військову агресію, затоплення житлових та сільськогосподарських територій, руйнування об'єктів критичної інфраструктури, а також з настанням теплого періоду року збільшується ризик ускладнення санітарно-епідемічної ситуації щодо виникнення гострих кишкових інфекційних захворювань та харчових отруєнь серед населення.
Наразі йдеться про захворювання, пов’язані з питною водою, поверхневими водоймами та річками, забрудненням ґрунту, продуктами харчування, які стають шляхом передачі багатьох збудників інфекції, а саме: дизентерія, сальмонельоз, лептоспіроз, холера, ботулізм, вірусний гепатит А, гельмінтози тощо.
Кишкові інфекції (отруєння) розвиваються досить швидко, через 6–48 годин від моменту зараження, але можуть мати і більш тривалий інкубаційний період. Зараження гельмінтами відбувається непомітно та набирає хронічний перебіг хвороби. В період поки розвивається захворювання, інфікована людина може переїхати на інші території регіонів і вже там стати джерелом інфекції для інших людей. Шляхи передачі - від хворої людини до здорової, через ряд продуктів харчування, контактні поверхні, забруднену воду. При цьому обставинами, що сприяють розповсюдженню збудника інфекції є відсутність умов дотримання особистої гігієни людини, відсутність води, немиті руки, несприятливі умови перебування.
За таких обставин та у стані стресу людина може не відразу розпізнати симптоми захворювання та своєчасно звернутися по допомогу. Це вкрай небезпечно, оскільки деякі збудники інфекцій є патогенними, особливо небезпечними та спричиняють ускладнення інших органів і систем в організмі людини, що може закінчитись летально (леспоспіроз, холера, ботулізм). Такі захворювання як гельмінтози навпаки тривалий час не виявляються, але інтоксикують організм та інфікують навколишнє середовище.
З огляду на вищевикладене, з метою попередження негативних наслідків для здоров’я людей, Головне управління Держпродспоживслужби в Кіровоградській області рекомендує населенню області дотримуватися кількох простих правил належної гігієни та безпечного харчування. Ці правила включають:
- ретельне миття рук, особливо перед приготуванням їжі та безпосередньо перед їжею,
- належну теплову обробку продуктів і їх вживання в їжу в гарячому вигляді,
- кип'ятіння або додаткову обробку питної води,
- обов'язкове використання засобів гігієни.
Для запобігання захворювань на гострі кишкові інфекції, холеру, ботулізм необхідно дотримуватись наступних правил:
- використовувати воду лише з перевірених безпечних вододжерел або ж кип’ячену воду та промислового виробництва або продезінфіковану відповідними засобами,
- вживати в їжу продукти, які пройшли ретельну теплову обробку. Готові харчові продукти, залишені протягом декількох годин при кімнатній температурі, без додаткового розігрівання можуть стати джерелом інфекції,
- не використовувати в їжу харчові продукти, якість яких викликає сумнів,
- не купувати продукти в місцях стихійної торгівлі, зокрема риби, яка може бути привезена із затоплених та посушених територій,
- не купатися у незнайомих водоймищах без течії, на стихійних пляжах, особливо у разі пошкоджень або захворювань шкіри, слизових оболонок на тілі людини,
- під час купання у водоймищах, річках не заковтувати воду, не купати домашніх тварин,
- на відпочинку дотримуватися елементарних правил особистої гігієни (ретельно мити руки, використовувати безпечну питну воду, вживати та використовувати харчові продукти після їх миття і відповідної обробки),
- вживати заходи щодо боротьби з мухами, проникнення комах до приміщень, так як вони можуть механічним шляхом переносити збудників інфекційних хвороб,
- уникати контактів з особами, які мають ознаки інфекційних кишкових захворювань (отруєнь).
Кип'ятіння найпростіший спосіб знешкодити небезпечних бактерій і хвороботворних мікроорганізмів, які гинуть при температурі, близької до ста градусів.
Бережіть себе та своїх близьких! При появі найменших симптомів гострих кишкових інфекцій чи отруєнь слід негайно звернутися за медичною допомогою! Не зволікайте та не соромтеся свого стану. Самолікування небезпечне для здоров’я!